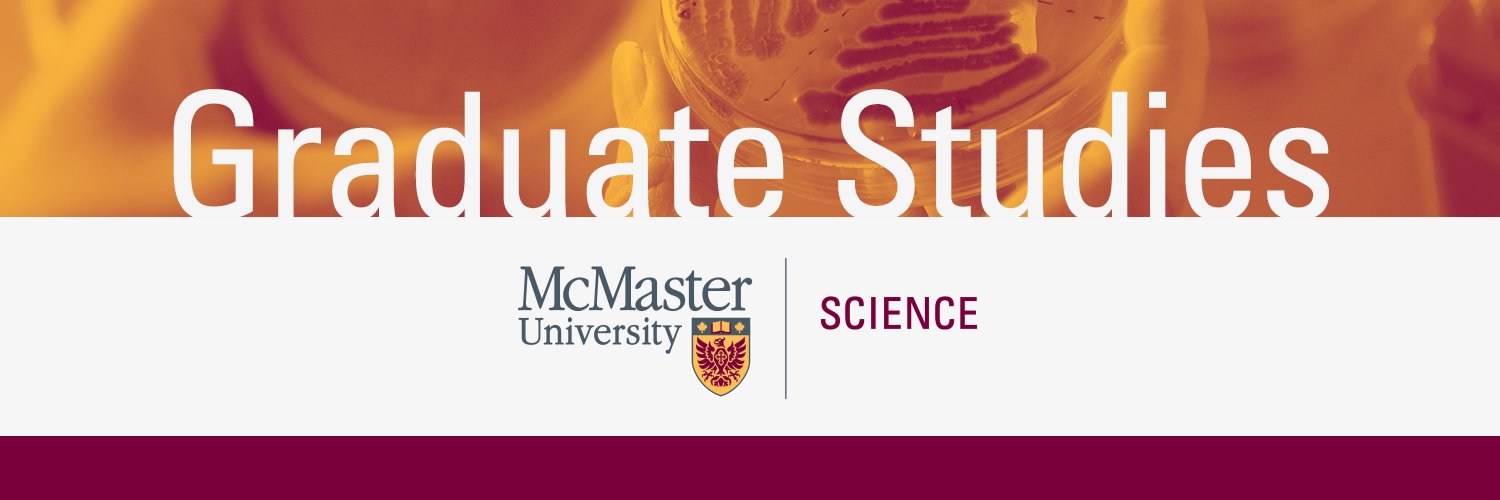
MacSciGrad banner

MacSciGrad
1.1K posts

MacSciGrad
@MacSciGrad
Graduate Studies @McMasterU's Faculty of Science



In the lead up to International Women’s Day, we’ve teamed up with @RBC on an evening to inspire female athletes to talk about the topics women in sport leadership are facing today. Among the 6 panelists will be Dr. Maureen Macdonald and TSN’s Lindsay Hamilton

“Like all children I was obsessively curious when I was young. I would spend hours reading books on science, philosophy, and history, hungry to know more ..." Read full story here: facebook.com/GradchairPhysA…. #ScientistsOfMcMaster @MacSciGrad @MacSciResearch @McMasterU

“I thought the transition moving from Quebec to Ontario would be much harder. I went to McGill for my undergraduate degree. Despite being in Montreal, ..." Read full story here: facebook.com/GradchairPhysA…. #ScientistsOfMcMaster @MacSciGrad @MacSciResearch @McMasterU

Start your week off right and register for the Alumni Social Event!! Register now before we sell out! Bit.ly/2tM3OOb @McMasterAlumni @mcmastersgs @McMasterScience @MacSciGrad @Cate_Maybrey

“My crystallizing moment where I knew what I wanted to do with my life happened when I was about 12 years old. I was on a trip, hiking through the mountains,..." Read full story here: facebook.com/GradchairPhysA…. #ScientistsOfMcMaster @MacSciGrad @MacSciResearch @McMasterU

“I’ve spent the last 4 years as a grade 12 science teacher. Before that I got my undergraduate degree in Engineering and worked in the USA as an engineer. ..." Read full story here: facebook.com/GradchairPhysA…. #ScientistsOfMcMaster @MacSciGrad @MacSciResearch @McMasterU


“I want to be a stay-at-home astronaut. I love space exploration, I love the idea of sending rockets into space, and I love all of the research that surrounds it,..." Read full story here: facebook.com/GradchairPhysA…. #ScientistsOfMcMaster @MacSciGrad @MacSciResearch @McMasterU

“It has been my dream to come to Canada. This is my first time here, and it’s only been a little more than a month, but I love it already. ..." Read full story here: facebook.com/GradchairPhysA…. #ScientistsOfMcMaster @MacSciGrad @MacSciResearch @McMasterU



“My mother is a cancer survivor, so in a very real way, cancer has defined my life and now defines my graduate degree. I am fascinated by cancer..." Read full story here: facebook.com/GradchairPhysA…. #ScientistsOfMcMaster @MacSciGrad @MacSciResearch @McMasterU





“Math tells us a story. It is our job as physicists to figure out what that story is, and how it relates to the world around us. That’s what I find most attractive about physics..." Read full story here: facebook.com/GradchairPhysA…. #ScientistsOfMcMaster @MacSciGrad @MacSciResearch



McMaster grad students: register to compete in the 2020 Three Minute Thesis competition! Share your research story – in 3 minutes or less – for a chance to win $$, represent McMaster at the provincial competition. More bit.ly/2S54dTY



